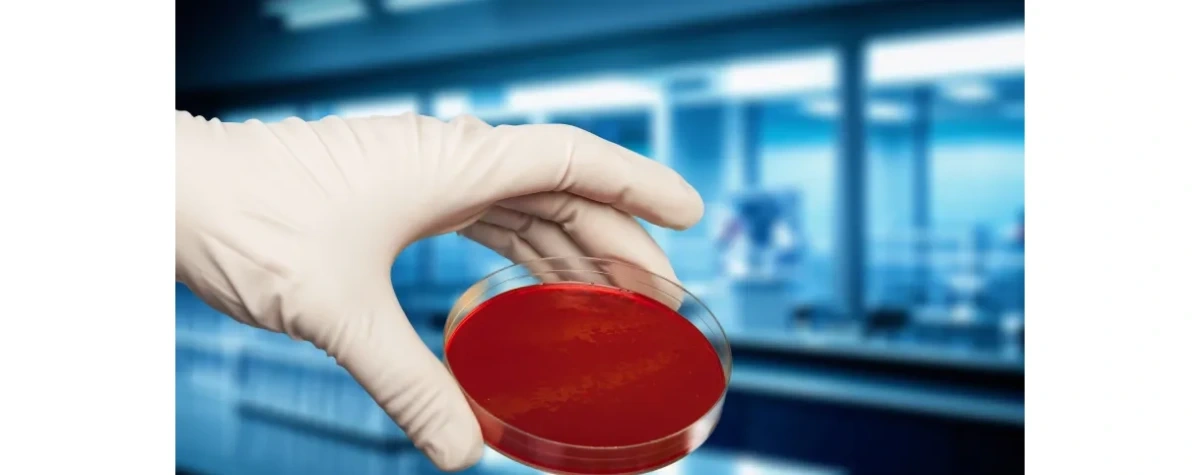
Gdańsk/ Polscy naukowcy opracowali metodę usuwania drobnoustrojów przy użyciu zimnej plazmy

Gdańsk/ Polscy naukowcy opracowali metodę usuwania drobnoustrojów przy użyciu zimnej plazmy
Nauka w PolsceNaukowcy z Uniwersytetu Gdańskiego, GUMed i Politechniki Wrocławskiej opracowali opatentowaną metodę usuwania groźnych drobnoustrojów z powierzchni płaskich przy użyciu zimnej plazmy, zmniejszając ryzyko zakażeń u ludzi i zwierząt.
Centrum Transferu Technologii UG podało, że metoda skutecznie eliminuje mikroorganizmy wywołujące infekcje skórne u ludzi i zwierząt, w tym Staphylococcus aureus, Staphylococcus epidermidis, Candida albicans i Dermatophilus congolensis. Technologia znajduje zastosowanie w sterylizacji powierzchni w szpitalach, laboratoriach i przestrzeniach hodowlanych.
Rozwiązanie opiera się na zimnej plazmie atmosferycznej (CAPP), generowanej w formie wyładowań barierowych (DBD) w postaci strugi gazowej. Wynalazek jest opatentowany w Europie (EPO) oraz w Polsce, co umożliwia jego szersze wdrożenie.
– Wynalazek pozwala skutecznie eliminować drobnoustroje z powierzchni, które często stanowią źródło zakażeń – powiedział dr hab. Wojciech Śledź z UG. Podkreślił, że trudne do gojenia rany u ludzi i zwierząt, zwłaszcza zakażone wielolekoopornymi szczepami bakterii, znacząco obniżają jakość życia i utrudniają leczenie. [...]
#nauka #drobnoustroje #mikroorganizmy #technologia #plazma #patent #uniwersytetgdanski #politechnikawroclawska #gdanskiuniwersytetmedyczny #naukawpolsce